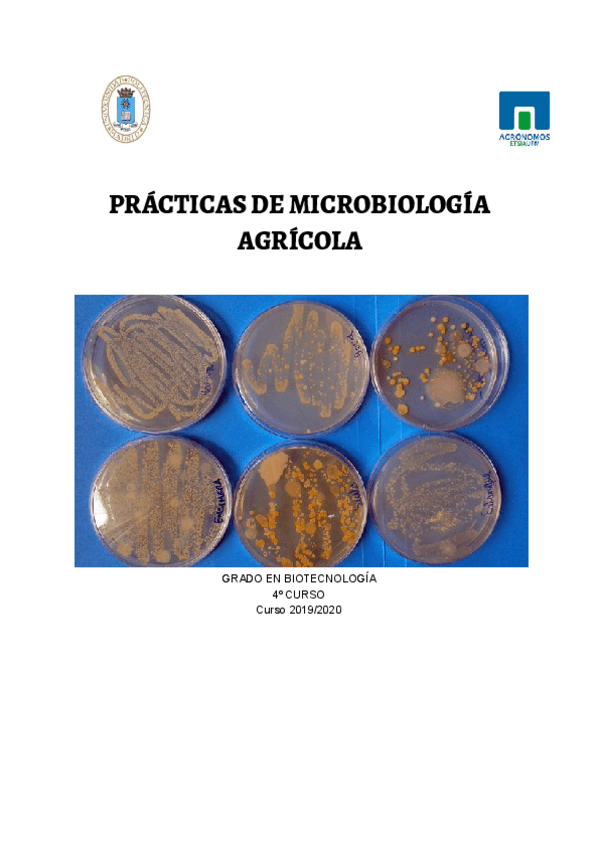

Microbiología Agrícola
Todo
Apuntes
chevron_left
chevron_right
apuntes
-
apunts y examen
He publicado nuevos apuntes de 3º Microbiología Agrícola: apunts y examen
apuntes
-
apuntes y preguntas ex.
He publicado nuevos apuntes de 3º Microbiología Agrícola: apuntes y preguntas ex.
apuntes
-
MICROBIOLOGIA AGRICOLA
He publicado nuevos apuntes de 3º Microbiología Agrícola: MICROBIOLOGIA AGRICOLA

¡Estás al día!
Has visto todos los archivos